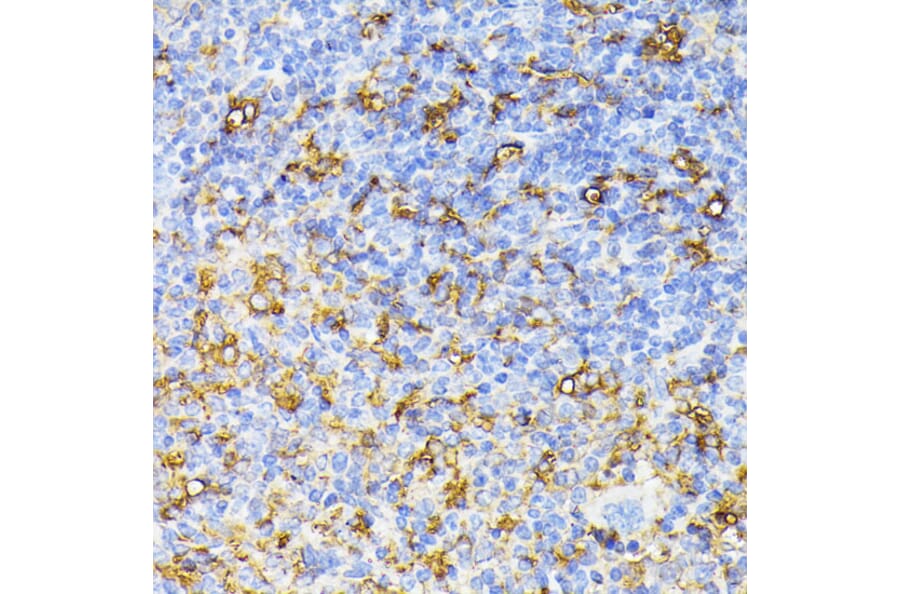
Anti-VEGF Receptor 1 Antibody (A17185) - IHC

Lucas Baumard, PhD | 23rd April 2025
Endothelial cells are a subset of Epithelial Cells that line all blood vessels within the human body. Here they form a single layer known as the endothelium, which regulates the transit of materials, including cells, into and out of the bloodstream. Endothelial cells also regulate important bodily functions such as angiogenesis, wound healing (hemostasis) and inflammation.
Whilst endothelial cells mostly spend their life embedded in the epithelium, they can detach from the endothelium, either due to damage or after differentiation.1 The abundance of these circulating endothelial cells in the blood is used as a biomarker of endothelial damage, senescence and aging or cancer.2
Endothelial cells are studied in the context of:
Figure 1: Structure of a human artery.
Endothelial cells can be identified by a number of markers which relate either to their function (wound healing, angiogenesis) or location (heart, brain etc.). Examples of some common, specific endothelial markers include:
Von Willebrand factor (VWF, Factor VIII) is a glycoprotein that is essential for hemostasis by mediating platelet adhesion and coagulation.3 VWF is found in plasma, platelets and in bodies within endothelial cells therefore is most often detected by ELISA in cell lysates or IHC stains. ELISA is often used for clinical diagnosis of Von Willebrand disease, one of the most common congenital bleeding abnormalities worldwide.4
CD34 is a phosphoglycoprotein expressed in blood and lymphatic vessel endothelial cells and on hematopoietic stem cells and endothelial cell progenitors in the bone marrow.5 The expression of CD34 can be split into two subpopulations (CD34high and CD34low), with CD34high cells associated with lower proliferation and increased CD34-derived, IL-33-dependent Treg proliferation.6 CD34 expression has been shown to be lost with the transition of endothelial cells to a 2D culture medium and over passages.7
Figure 2: IHC of human pancreas tissue stained with Anti-Von Willebrand Factor Antibody [3E2D10] (A250320).
Figure 3: Flow cytometry analysis of human peripheral blood stained with Anti-CD34 Antibody [QBEnd-10] - BSA and Azide free (A85659).
CD146 (or melanoma cell adhesion molecule, MCAM) is highly expressed in endothelial cells and to a lesser extent in smooth muscle cells, lymphocytes and fibroblasts.8 The protein is important for mediating cell-cell and cell-ECM binding, regulating cell growth survival and migration.9 It is also associated with angiogenesis and differentiation through its role as a co-receptor with VEGFR2 and as a Wnt receptor.10 CD146 is more highly expressed in embryonic vs adult tissue.11 In adult tissue it is found highly expressed in various cancers10, with a slightly different extracellular domain allowing it to be differentiated from normal tissue CD146.12
Endothelial cells derive from the mesoderm during gastrulation, differentiating into arterial, venous, capillary, and lymphatic endothelial cells, each with distinct phenotypes.13 After birth, endothelial cells derive from endothelial progenitors of the bone marrow.5
Vascular endothelial growth factor (VEGF) is an important protein for vascular development (veins, arteries), cell survival, and angiogenesis.14 The VEGF receptors VEGFR-1 and VEGFR-2 are expressed almost exclusively in endothelial cells.15 VEGF plays an important role in cancer survival through angiogenesis, allowing the tumor to grow and spread.16
CD45 is normally only expressed on immune cells in adult humans. However, endothelial-to-mesenchymal transition (EndoMT) is a process where endothelial cells take on properties and markers of mesenchymal cells and is characterized by renewed expression of CD45.17 EndoMT is a normal feature during development, but in mature endothelial cells it can lead to various cardiac and circulatory diseases such as atherosclerosis and hypertension. CD45 is therefore a useful biomarker of EndoMT in endothelial cells.
Figure 4: IHC of mouse spleen tissue stained with Anti-VEGF Receptor 1 Antibody (A17185).
Figure 5: ICC/IF of Jurkat cells stained with Anti-CD45 Antibody [135-4C5] (A249815).
CD31 and Angiogenesis
Endothelial cells possess the ability to repair and renew the lining of existing blood vessels as well as create new ones (angiogenesis). New blood vessels are grown from existing ones (Figure 6) and this occurs continuously from birth to death. Angiogenesis involves extracellular matrix degradation, increased vascular permeability, proliferation, migration, and invasion of endothelial cells, followed by the formation of new vessels (Figure 6).
Figure 6: The process of angiogenesis. Edited and reproduced under Creative Commons 4.0 CC-BY from Laschke, MW et al. Replacement in angiogenesis research: Studying mechanisms of blood vessel development by animal-free in vitro, in vivo and in silico approaches. Front. Physiol. 13 (2022).
The stimulation of angiogenesis is seen as useful in treating diseases such as ischemia, arterial disease and wound healing. On the other hand, inhibiting angiogenesis is important in cancer, rheumatoid arthritis among other diseases.18
CD31 (PECAM-1) is a member of the PECAM-1 superfamily that is highly expressed on endothelial cells and overexpressed in cancer cells.19 The protein is concentrated at endothelial cell-cell borders where it acts as a mechanosensor, regulates leukocyte trafficking,20 and is essential for maintenance of the endothelial cell barrier.21 CD31 is vital for angiogenesis: antibodies against CD31 have been shown to block neovascularization and de novo blood tube formation in rats22 and is significantly increased in some cancers.23,24 CD31 activation has also been shown to promote cell survival, abrogating inflammation-induced apoptosis25 in healthy tissue and chemotherapy-induced cell death in cancer.26
Markers of Endothelial Barrier Regulation
Endothelial cells form a thin, malleable barrier between luminal contents of vessels and tissue. One important example of this is that of the brain microvascular endothelial cells, which regulate the movement of cells and material from the bloodstream into the blood-brain barrier. This barrier acts to prevent the ingress of harmful bacteria, viruses, diseased cells, and blood components, but also regulates migration of leukocytes and maintains electrolyte and fluid balance.
Venular endothelial cells regulate the migration of leukocytes from the blood into tissues through the expression of adhesion markers (e.g. P- and E-selectin, vascular cell-adhesion molecule 1 (VCAM1)) necessary for leukocyte attachment.27 Leukocytes can migrate through junctions or (more rarely) directly through endothelial cells.28
Adhesion Markers
CD144/ VE-cadherin is an adhesion molecule located at endothelial cell-cell junctions and helps regulate permeability through the endothelial cell barrier. CD144 is a member of the type II cadherin family, whereas E-, N-, P- and C-cadherin (see Epithelial Cell Markers) belong to the type 1 family.29 CD144 is the only endothelial cadherin. Antibodies against CD144 are of interest clinically in cancer due CD144’s anti-apoptotic and pro-proliferative activity, but have to be balanced against its vital role in maintaining cell-cell junctions.
Figure 7: Flow cytometry analysis of HUVEC cells stained with Anti-VE Cadherin Antibody [55-7H1] (PE) (A121858).
CD144 demonstrates an interesting transitional expression: it is temporarily lost at endothelial contacts during monocyte transmigration,30 likely due to VEGF signaling31 as CD144 has been shown to associate with VEGFR-2.32,33 The interaction is not fully understood but it seems to increase proliferation and decrease apoptosis.32,33
CD144 plays an essential role in angiogenesis, with CD144- mice dying at gestation due to vascular defects,34 with later research demonstrating a role in maintaining (not creating) nascent blood vessels.35
Leukocyte Trafficking Markers
Endothelial cells are also important cells in the regulation of immune responses by controlling the movement of leukocytes along blood vessels and through the endothelium and into tissues.
Lymphatic vessel endothelial hyaluronan receptor 1 (LYVE-1) is a transmembrane protein expressed on endothelial cells of the lymphatic system and liver as well as some more specialized tissues such as kidney, cortical neurons, and islets of Langerhans.5 It is a marker often used to differentiate blood and lymphatic vessels.36 Though originally thought to act only as a part of the hyaluronan catabolism factor (acting as a receptor), its role in lymphatic trafficking and leucocyte migration has recently been elucidated. Endothelial, lymphatic LYVE-1 has been shown to act as a docking receptor for dendritic cells, mediate macrophage migration and activate lymph nodes.37-39
Plasmalemma vesicle associated protein (PLVAP) is the key protein in endothelial cell vesicles (caveolae),40 which mediate transcytosis of molecules across the endothelial cell barrier. It is generally endothelium specific. The density of these vesicles varies across endothelial cell populations, being rarest in the brain and most common in heart, lung, and skeletal muscle.41,42 PLVAP is an important protein for cardiac development and hemo- and homeostasis, as well as leukocyte migration and angiogenesis.43-46 On account of these roles, PLVAP is associated with cancer and brain disease.
Endothelial Regulation of Blood Flow
Endothelial cells express mechanoreceptors which allow them to detect the flow of blood across them and act to alter blood flow by altering the blood vessel.47 They also regulate blood flow by preventing blood coagulation through the downregulation of the factor-VIIa–tissue-factor complex.27 Factor VIIa is a plasma coagulation factor which initiates a cascade leading to platelet activation, fibrin deposition and the formation of a clot. The factor has been shown to bind to endothelial cell protein C receptor.48 Factor VIIa is released by endothelial cells into the bloodstream and so can be detected either by ELISA or using IHC to measure un-released levels in cells.
The methods to study endothelial populations are broadly similar to those for epithelial cells; namely immunohistochemistry (IHC), flow cytometry and ELISA.
IHC is a tool that allows for the rapid identification of specific epithelial sub-types as well and the change in expression of surface markers important for disease diagnosis and prognosis. Cross sections of vessels allow the easy distinction of the endothelium from the other layers of cells that make up the circulatory system. Leukocyte migration across and along this barrier can be visualized by IHC.
Flow cytometry allows the phenotyping and characterization of isolated endothelial cells as well as the study of internal proteins through intracellular staining.
Because endothelial cells sit directly facing the lumen, contain secretory vesicles and release factors into the bloodstream, ELISA allows for the easy detection and quantification of proteins released from endothelial cells.
Diagrams created with BioRender.com.

![Anti-Von Willebrand Factor Antibody [3E2D10] (A250320) - IHC](https://cdn.antibodies.com/image/catalog/250/A250320_1.jpg?profile=product_image)
![Anti-CD34 Antibody [QBEnd-10] - BSA and Azide free (A85659) - Flow cytometry](https://cdn.antibodies.com/image/catalog/85/A85659_135.jpg?profile=product_image)
![Anti-CD45 Antibody [135-4C5] (A249815) - ICC/IF](https://cdn.antibodies.com/image/catalog/249/A249815_3.jpg?profile=product_image)

![Anti-VE Cadherin Antibody [55-7H1] (PE) (A121858) - Flow cytometry](https://cdn.antibodies.com/image/catalog/121/A121858_1.jpg?profile=product_image)